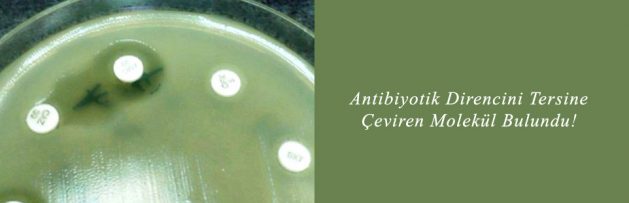

Bilim insanları antibiyotik direncini tersine çeviren bir molekül geliştirmeyi başardı.
![]()
21 Ocak 2017
Geçtiğimiz günlerde ABD’de mevcut tüm antibiyotiklere dirençli süpermikrop infeksiyonu nedeniyle bir kadının ölmesinin ardından, yeni molekül antibiyotik direncine karşı büyük bir başarı olarak görülüyor.
Yeni Delhi Metallo-beta-laktamaz (NDM-1) adıyla bilinen bir enzim toksik yapısı nedeniyle en son başvurulan karbapeneme bile bakterilerin direnç geliştirmelerine neden oluyor.
Yeni antibiyotik geliştirmenin zorluğuna vurgu yapan Oregon State Üniversitesi’nden araştırmacı Bruce Geller “Bize kalan elimizdeki antibiyotiklere modifikasyonlar yapmak ancak mikroorganizmalar kimyasal olarak modifiye edilmiş antibiyotiklere de direnç geliştiriyorlar” diye konuşuyor.
Geller ve arkadaşları bunu önlemek için NDM-1’e saldırarak pek çok tip bakteride antibiyotik direncini tersine çeviren bir molekül geliştirdi. Bu sayede artık işe yaramaz olarak kabul edilen antibiyotikler yeniden kullanılabilecek.
NDM-1’i devreden çıkaran molekül peptid-konjuge fosforodiyamidat morfolino oligomer (PPMO) adıyla biliniyor.
Daha önce üzerinde çalışılan PPMO molekülleri yalnızca belirli türde bakteriler üzerinde etkili olurken yeni molekül bu açıdan farklılık gösteriyor. Farklı bakteri türlerindeki aynı gen ve direnç mekanizması üzerinde etkili oluyor.
Geller ve ekibi yeni PPMO’yu NDM-1 içerdiği ve karbapeneme dirençli olduğu bilinen farklı bakteri türleri üzerinde denemiş. Meropenem üzerinde denenen molekülün antibiyoiğin bakteri öldürme özelliğini geri almasını sağladığını bulmuşlar.
Antibiyotiğe dirençli E. coli ile infekte farelerde yeni PPMO ve meropenem kombinasyonu infeksityon üzerinde etkili tespit edilirken farelerin sağkalım oranı artmış.
Araştırma Journal of Antimicrobial Chemotherapy adlı dergide yayımlandı.
Haberin Tam Metni için [Tıklayınız]
Peptide-conjugated phosphorodiamidate morpholino oligomer (PPMO) restores carbapenem susceptibility to NDM-1-positive pathogens in vitro and in vivo
Published: 15 December 2016